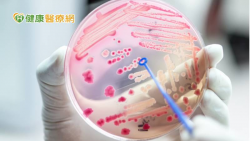

健康醫療網 - 所有的文章 - 共有 15410 篇文章 搜尋時間 0.021 秒
這種癌症好好治療,多數病友可存活10、20年以上
2021-12-13 10:00:00 by 健康醫療網 @ 健康醫療網 [引用來源]
 中國醫藥大學附設醫院內科部副主任葉士芃提醒,慢性淋巴性白血病的病程進展雖然緩慢,但病患還是需要接受治療,才能避免病情急轉直下。 「葉醫師,我得了血癌,是不是沒救了?」在血液腫瘤學專家中國醫藥大學附設醫院內科部副主任葉士芃的診間,一名年約65歲的阿伯一聽到自己確診慢性淋巴性白血病,便認為自己得血癌而灰心喪志。 這時,葉士芃醫師向阿伯解釋,他說,這種...... [閱讀更多]
中國醫藥大學附設醫院內科部副主任葉士芃提醒,慢性淋巴性白血病的病程進展雖然緩慢,但病患還是需要接受治療,才能避免病情急轉直下。 「葉醫師,我得了血癌,是不是沒救了?」在血液腫瘤學專家中國醫藥大學附設醫院內科部副主任葉士芃的診間,一名年約65歲的阿伯一聽到自己確診慢性淋巴性白血病,便認為自己得血癌而灰心喪志。 這時,葉士芃醫師向阿伯解釋,他說,這種...... [閱讀更多]
狂吃瀉藥解便祕無效 竟是子宮肌瘤壓迫大腸惹禍!
2021-12-13 09:40:00 by 健康醫療網 @ 健康醫療網 [引用來源]
 台北中山醫院婦產科主任暨海扶刀中心負責人鍾國騰醫師表示,子宮肌瘤壓迫到大腸可能引起便秘,患者如有出現疑似肌瘤症狀,應積極就診定期追蹤。 一名33歲的OL香香(化名)長期排便不順,主述平均一週才會有一次便意,起初以為是長時間坐辦公室缺乏運動造成,也開始注重高纖飲食及喝水量,希望幫助腸胃蠕動,不料便秘問題仍然困擾著她。後來開始靠服用瀉藥幫助排便,但幾個月過...... [閱讀更多]
台北中山醫院婦產科主任暨海扶刀中心負責人鍾國騰醫師表示,子宮肌瘤壓迫到大腸可能引起便秘,患者如有出現疑似肌瘤症狀,應積極就診定期追蹤。 一名33歲的OL香香(化名)長期排便不順,主述平均一週才會有一次便意,起初以為是長時間坐辦公室缺乏運動造成,也開始注重高纖飲食及喝水量,希望幫助腸胃蠕動,不料便秘問題仍然困擾著她。後來開始靠服用瀉藥幫助排便,但幾個月過...... [閱讀更多]
簡單生活七件事(五)中風才知高血壓 患者越來越年輕
2021-12-13 09:00:00 by 健康醫療網 @ 健康醫療網 [引用來源]
 高血壓常見的症狀會有頭痛、頭暈、耳鳴、心悸等,嚴重者會噁心、嘔吐、昏迷。不過大部分毫無症狀,陳晉誼主任說,甚至有人第一次發生症狀,就是中風。 中風才知高血壓!高血壓是中風的高危險群,高雄醫學大學附設中和紀念醫院神經部腦中風中心趙雅琴教授表示,血壓每多10mmHg,中風風險就增30%,且3、40歲中風的患者越來越多。台北市立萬芳醫院神經內科中風防治中心主...... [閱讀更多]
高血壓常見的症狀會有頭痛、頭暈、耳鳴、心悸等,嚴重者會噁心、嘔吐、昏迷。不過大部分毫無症狀,陳晉誼主任說,甚至有人第一次發生症狀,就是中風。 中風才知高血壓!高血壓是中風的高危險群,高雄醫學大學附設中和紀念醫院神經部腦中風中心趙雅琴教授表示,血壓每多10mmHg,中風風險就增30%,且3、40歲中風的患者越來越多。台北市立萬芳醫院神經內科中風防治中心主...... [閱讀更多]
周遭親友有反社會人格嗎? 這個測驗一測便知
2021-12-13 08:00:00 by 健康醫療網 @ 健康醫療網 [引用來源]
 曾經有國外研究,大約每25個人中,就可能有一個人是反社會人格。 曾經有國外研究,大約每25個人中,就可能有一個人是反社會人格。這種說法或許有點令人不敢置信,但其實,有很多的反社會人格就暗藏在你我周遭,甚至還是身邊親近的伴侶或同仁。 反社會人格不一定會犯罪 事業成功也可能有反社會傾向 做感情諮商的時候,我發現很多當事人敘述情人或伴侶的行為都很...... [閱讀更多]
曾經有國外研究,大約每25個人中,就可能有一個人是反社會人格。 曾經有國外研究,大約每25個人中,就可能有一個人是反社會人格。這種說法或許有點令人不敢置信,但其實,有很多的反社會人格就暗藏在你我周遭,甚至還是身邊親近的伴侶或同仁。 反社會人格不一定會犯罪 事業成功也可能有反社會傾向 做感情諮商的時候,我發現很多當事人敘述情人或伴侶的行為都很...... [閱讀更多]
8旬嬤身體硬朗 例行健檢竟揪出「壺腹腫瘤」
2021-12-12 16:00:00 by 健康醫療網 @ 健康醫療網 [引用來源]
 85歲侯姓阿嬤有預防勝於治療的觀念,每年都會進行例行性健檢,今年在透過無痛腸胃鏡檢查時,意外發現壺腹腫瘤,經切片檢查後發現是良性的壺腹腺瘤,但不排除有癌化的可能,因此醫師使用內視鏡將其切除,恢復健康。 85歲侯姓阿嬤有預防勝於治療的觀念,每年都會進行例行性健檢,今年在透過無痛腸胃鏡檢查時,意外發現壺腹腫瘤,經切片檢查後發現是良性的壺腹腺瘤,但不排除有癌...... [閱讀更多]
85歲侯姓阿嬤有預防勝於治療的觀念,每年都會進行例行性健檢,今年在透過無痛腸胃鏡檢查時,意外發現壺腹腫瘤,經切片檢查後發現是良性的壺腹腺瘤,但不排除有癌化的可能,因此醫師使用內視鏡將其切除,恢復健康。 85歲侯姓阿嬤有預防勝於治療的觀念,每年都會進行例行性健檢,今年在透過無痛腸胃鏡檢查時,意外發現壺腹腫瘤,經切片檢查後發現是良性的壺腹腺瘤,但不排除有癌...... [閱讀更多]
研究發現「影響食慾關鍵」 還能避免報復性復胖
2021-12-12 14:00:00 by 健康醫療網 @ 健康醫療網 [引用來源]
 目前科學性減肥多著重於解釋「大腦」對於食慾的影響,「腦內減肥」、「欺騙大腦瘦身」、「易胖腦」等皆針對大腦進行調節控制,但令人意想不到的是最新研究顯示,小腦會影響食慾控制。 貪吃可能不只是大腦惹的禍!美國國家衛生研究院發表最新發現,腦細胞有效抑制飢餓、控制食量,將會為肥胖、過量進食帶來更新的治療。目前科學性減肥多著重於解釋「大腦」對於食慾的影響,「腦內減...... [閱讀更多]
目前科學性減肥多著重於解釋「大腦」對於食慾的影響,「腦內減肥」、「欺騙大腦瘦身」、「易胖腦」等皆針對大腦進行調節控制,但令人意想不到的是最新研究顯示,小腦會影響食慾控制。 貪吃可能不只是大腦惹的禍!美國國家衛生研究院發表最新發現,腦細胞有效抑制飢餓、控制食量,將會為肥胖、過量進食帶來更新的治療。目前科學性減肥多著重於解釋「大腦」對於食慾的影響,「腦內減...... [閱讀更多]
濫用抗生素助長超級細菌! 中正大學研發「抗菌敷料」救命
2021-12-12 12:00:00 by 健康醫療網 @ 健康醫療網 [引用來源]
抗生素的發現拯救無數生命,卻也帶來新的危機!抗生素的濫用養出了「超級細菌」,甚至讓人類在未來面臨無藥可醫的窘境。對此,24位來自不同學院的中正大學學生利用合成生物學,設計一款能對抗超級細菌的抗菌敷料,用物理穿透的方式殺菌,傷口癒合的同時也能避免產生抗藥性。 抗生素的發現拯救無數生命,卻也帶來新的危機!抗生素的濫用養出了「超級細菌」,甚至讓人類在未來面臨...... [閱讀更多]
抗生素的發現拯救無數生命,卻也帶來新的危機!抗生素的濫用養出了「超級細菌」,甚至讓人類在未來面臨無藥可醫的窘境。對此,24位來自不同學院的中正大學學生利用合成生物學,設計一款能對抗超級細菌的抗菌敷料,用物理穿透的方式殺菌,傷口癒合的同時也能避免產生抗藥性。 抗生素的發現拯救無數生命,卻也帶來新的危機!抗生素的濫用養出了「超級細菌」,甚至讓人類在未來面臨...... [閱讀更多]
有效降低家暴發生機率 從施暴者心理下手
2021-12-12 10:00:00 by 健康醫療網 @ 健康醫療網 [引用來源]
 通常暴力行為是在成長過程中習得,若能在有徵兆但未發生家暴事件前積極面對和處理,才有能從源頭改善情況的機會。 家庭暴力事件近來隨著媒體聚焦,再度被放上檯面討論,但其實一直以來此問題都困擾著許多人,且往往是持續、循環地發生,不但不會自動停止,更有可能日漸嚴重。為了避免雙方關係與問題隨時間的拉長而持續惡化,若能在出現徵兆但未發生家暴事件前積極面對和處理,才有...... [閱讀更多]
通常暴力行為是在成長過程中習得,若能在有徵兆但未發生家暴事件前積極面對和處理,才有能從源頭改善情況的機會。 家庭暴力事件近來隨著媒體聚焦,再度被放上檯面討論,但其實一直以來此問題都困擾著許多人,且往往是持續、循環地發生,不但不會自動停止,更有可能日漸嚴重。為了避免雙方關係與問題隨時間的拉長而持續惡化,若能在出現徵兆但未發生家暴事件前積極面對和處理,才有...... [閱讀更多]
健保署攜手臺大醫院 導入AI開發心臟疾病診斷及預測模式
2021-12-12 08:00:00 by 健康醫療網 @ 健康醫療網 [引用來源]
 衛生福利部中央健康保險署與臺大醫院共同簽署合作備忘錄,臺大醫院將利用健保大數據開發心臟血管疾病診斷及預後AI預測模型,未來雙方將建置全球首個以影像資訊為基礎的心血管風險資料庫,藉由「全民健保行動快易通|健康存摺」APP,即能瞭解本身是否為心臟病高風險族群。 全民健保開辦至今已滿26年,歷年來所累積高價值的巨量就醫資料,是台灣發展大數據分析與醫療人工智慧...... [閱讀更多]
衛生福利部中央健康保險署與臺大醫院共同簽署合作備忘錄,臺大醫院將利用健保大數據開發心臟血管疾病診斷及預後AI預測模型,未來雙方將建置全球首個以影像資訊為基礎的心血管風險資料庫,藉由「全民健保行動快易通|健康存摺」APP,即能瞭解本身是否為心臟病高風險族群。 全民健保開辦至今已滿26年,歷年來所累積高價值的巨量就醫資料,是台灣發展大數據分析與醫療人工智慧...... [閱讀更多]
奇美醫學中心攜手長照機構 創「三好」安寧療護助善終
2021-12-11 16:00:00 by 健康醫療網 @ 健康醫療網 [引用來源]
 在臺灣的長照機構有許多長輩,高齡、多病、臥床,生命接近終點,卻一再被送進急診、加護病房,折騰到不成人形,而無法善終。奇美醫學中心於104至105年承接衛生福利部「推廣安寧緩和醫療社區照護模式試辦計畫」,舉辦社區安寧教育訓練,協助並輔導乙類安寧居家服務。 在臺灣的長照機構有許多長輩,高齡、多病、臥床,生命接近終點,卻一再被送進急診、加護病房,折騰到不成人...... [閱讀更多]
在臺灣的長照機構有許多長輩,高齡、多病、臥床,生命接近終點,卻一再被送進急診、加護病房,折騰到不成人形,而無法善終。奇美醫學中心於104至105年承接衛生福利部「推廣安寧緩和醫療社區照護模式試辦計畫」,舉辦社區安寧教育訓練,協助並輔導乙類安寧居家服務。 在臺灣的長照機構有許多長輩,高齡、多病、臥床,生命接近終點,卻一再被送進急診、加護病房,折騰到不成人...... [閱讀更多]

